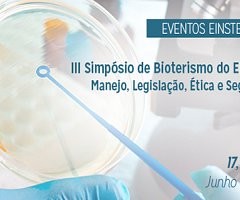
III Simpósio​ d​e Biot​erismo ​​d​o Einstein – ​Manejo, ​Legislação, Ética e​ Segurança​

2015
-
-
-
Ganador del Sorteo del Libro Genetics of the Mouse
13 January 2015 -
-
Curso sobre animales de Laboratorio XVII Edición (Argentina)
13 January 2015 -
-
Un implante flexible hace andar a ratones paralíticos
11 January 2015 -
Libro Comisión Nacional de Experimentación Animal (Uruguay)
11 January 2015
Página
7 de 7
Anterior